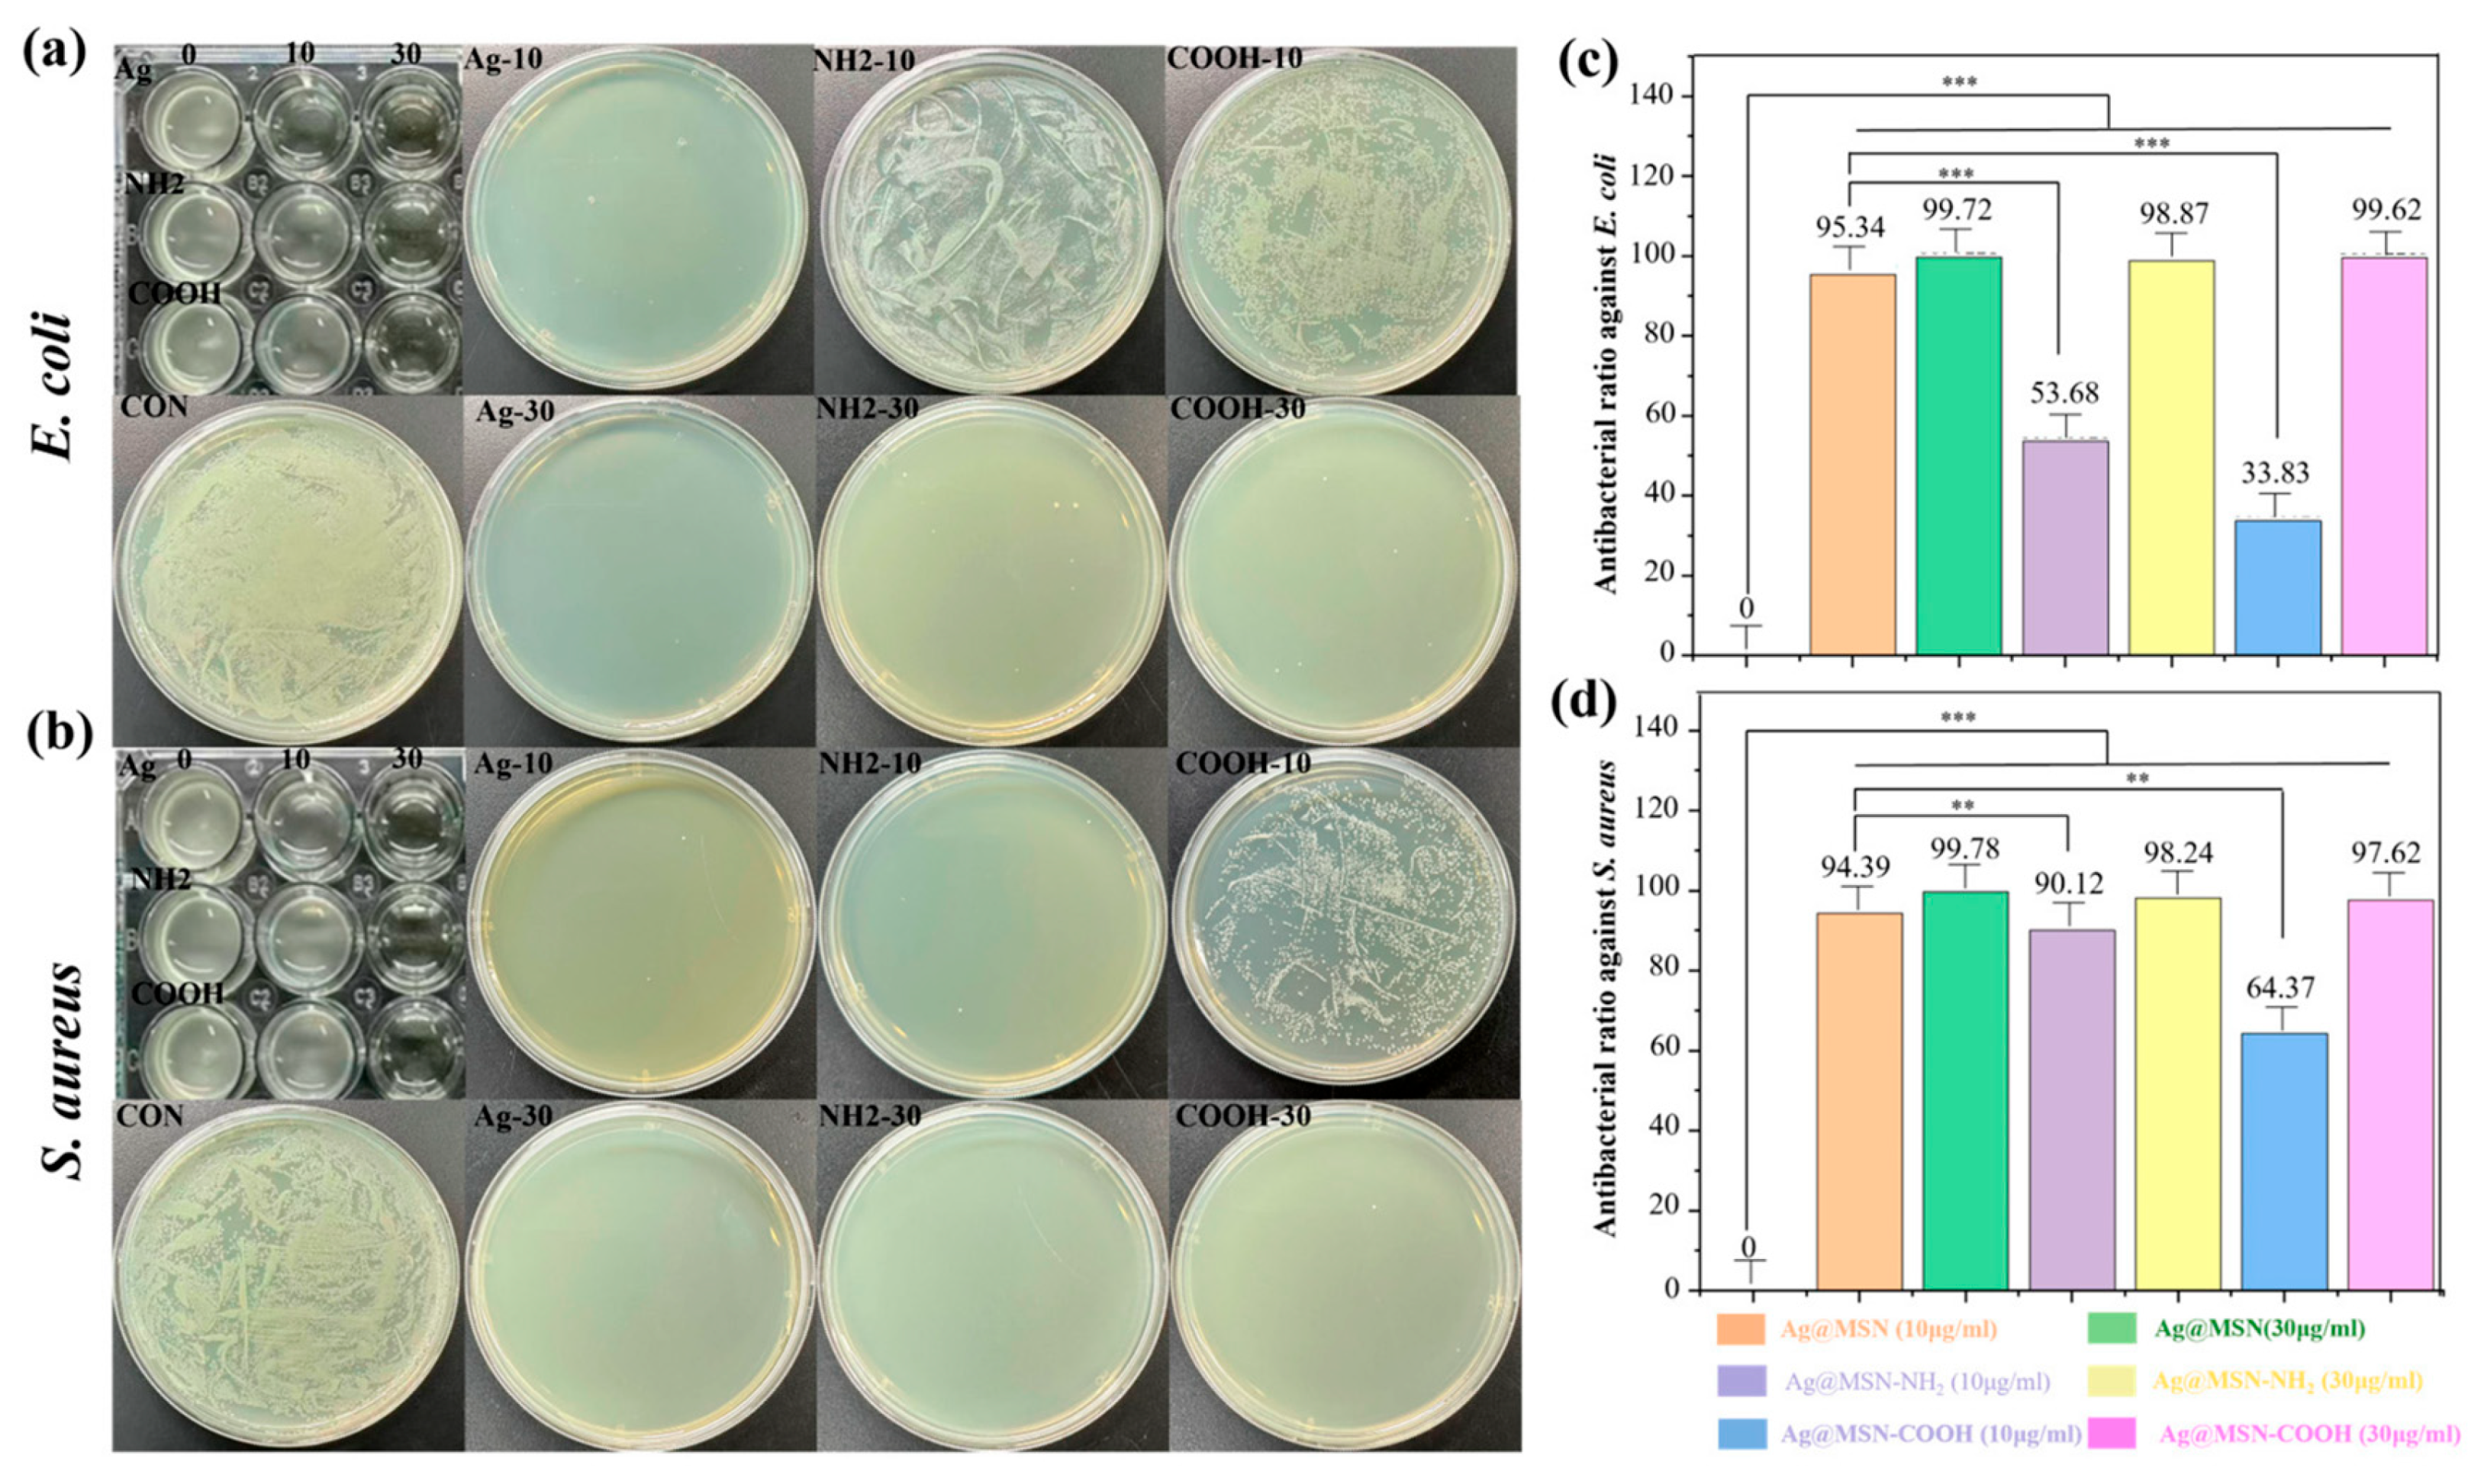
Chemistry 07 00146 g005

Sustained Release of Antibacterial Therapeutic Elements from Functionalized Mesoporous Silica-Coated Silver Nanoparticles for Bone Tissue Engineering
Abstract
1. Introduction
2. Experimental Section
2.1. Materials
2.2. Synthesis of Ag@MSNs
2.3. Functionalization of Ag@MSNs
2.3.1. Synthesis of Amino-Functionalized Ag@MSNs (Ag@MSNs-NH2)
2.3.2. Synthesis of Carboxylic Group-Functionalized Ag@MSNs (Ag@MSNs-COOH)
2.4. Material Characterization
2.5. Assessment of Ag Loading and Release Profiles
2.6. Assessment of Antibacterial Properties
2.7. In Vitro Study
Cytotoxicity
2.8. Statistical Analysis
3. Results and Discussion
3.1. Characterization of MSNs and Functionalized Ag@MSNs
3.2. Ag Ion Release Study
3.3. Antibacterial Study
3.4. Cell Compatibility Study
4. Conclusions
Supplementary Materials
Author Contributions
Funding
Data Availability Statement
Conflicts of Interest
References
- Feng, P.; Zhao, R.; Tang, W.; Yang, F.; Tian, H.; Peng, S.; Pan, H.; Shuai, C. Structural and Functional Adaptive Artificial Bone: Materials, Fabrications, and Properties. Adv. Funct. Mater. 2023, 33, 202214726. [Google Scholar] [CrossRef]
- Zhao, D.; Zhu, T.; Li, J.; Cui, L.; Zhang, Z.; Zhuang, X.; Ding, J. Poly(lactic-co-glycolic acid)-based composite bone-substitute materials. Bioact. Mater. 2021, 6, 346–360. [Google Scholar] [CrossRef] [PubMed]
- Zhang, Y.; Wu, C.; Zhao, Y.; Yu, J.; Han, L.; Jiang, X.; Yang, J.; Zhang, S.; Han, J.; Chen, Q. NIR responsive electrospun composite membranes for on-demand delivery of Ag ions to enhance treatment of bacteria-infected wounds. Chem. Eng. J. 2022, 514, 163428. [Google Scholar] [CrossRef]
- Wang, Z.; Liu, X.; Duan, Y.; Huang, Y. Infection microenvironment-related antibacterial nanotherapeutic strategies. Biomaterials 2022, 280, 121249. [Google Scholar] [CrossRef]
- Chatterjee, S.; Lou, X.Y.; Liang, F.; Yang, Y.-W. Surface-functionalized gold and silver nanoparticles for colorimetric and fluorescent sensing of metal ions and biomolecules. Coord. Chem. Rev. 2022, 459, 214461. [Google Scholar] [CrossRef]
- Liu, J.T.; Huang, J.; Zhang, L.; Lei, J. Multifunctional metal-organic framework heterostructures for enhanced cancer therapy. Chem. Soc. Rev. 2021, 50, 1188–1218. [Google Scholar] [CrossRef]
- Xie, Z.; Dai, C.; Gao, X.; Su, X.; Luo, Y.; Guo, X.; Li, Y.; Lin, Z.; Huang, S.; Jiang, W. Bioinspired multifunctional peptides integrated with anti-infective, immunomodulatory and osteogenic activities for infectious bone regeneration. Chem. Eng. J. 2025, 503, 158256. [Google Scholar] [CrossRef]
- Yuan, Z.; Wan, Z.; Gao, C.; Wang, Y.; Huang, J.; Cai, Q. Controlled magnesium ion delivery system for in situ bone tissue engineering. J. Control. Release 2022, 350, 360–376. [Google Scholar] [CrossRef]
- Liao, J.; Wang, L.; Ding, S.; Tian, G.; Hu, H.; Wang, Q.; Yin, W. Molybdenum-based antimicrobial nanomaterials: A comprehensive review. Nano Today 2023, 50, 101875. [Google Scholar] [CrossRef]
- Rajendran, A.K.; Anthraper, M.S.J.; Hwang, N.S.; Rangasamy, J. Osteogenesis and angiogenesis promoting bioactive ceramics. Mater. Sci. Eng. R Rep. 2024, 159, 100801. [Google Scholar] [CrossRef]
- Mu, Y.; Du, Z.; Gao, W.; Xiao, L.; Crawford, R.; Xiao, Y. The effect of a bionic bone ionic environment on osteogenesis, osteoimmunology, and in situ bone tissue engineering. Biomaterials 2024, 304, 122410. [Google Scholar] [CrossRef] [PubMed]
- Gai, K.; Zhang, T.; Xu, Z.; Li, G.; He, Z.; Meng, S.; Shi, Y.; Zhang, Y.; Zhu, Z.; Pei, X.; et al. Biomimetic management of bone healing stages: MOFs induce tunable degradability and enhanced angiogenesis-osteogenesis coupling. Chem. Eng. J. 2024, 493, 152296. [Google Scholar] [CrossRef]
- Jian, Y.; Chen, X.; Ahmed, T.; Shang, Q.; Zhang, S.; Ma, Z.; Yin, Y. Toxicity and action mechanisms of silver nanoparticles against the mycotoxin-producing fungus Fusarium graminearum. J. Adv. Res. 2022, 38, 1–12. [Google Scholar] [CrossRef]
- Rengasamy, G.; Mahalingam, S. Multifunctional composite film of chitosan/reduced graphene oxide infused silver nanoparticle for antibacterial and cytotoxic effects on HeLa cells. Int. J. Biol. Macromol. 2025, 321, 146356. [Google Scholar] [CrossRef]
- Wang, W.; Yu, Z.L.; Lin, M.S.; Mustapha, A. Toxicity of silver nanoparticle-incorporated bacterial nanocellulose to human cells and intestinal bacteria. Int. J. Biol. Macromol. 2023, 241, 124705. [Google Scholar] [CrossRef]
- Dong, Y.S.; Xiao, H.; Wang, J.; Yang, T.; Kang, N.; Huang, J.; Cui, W.; Liu, Y.; Yang, Q.; Wang, S. Sustained release silicon from 3D bioprinting scaffold using silk/gelatin inks to promote osteogenesis. Int. J. Biol. Macromol. 2023, 234, 123659. [Google Scholar] [CrossRef]
- Liu, L.; Feng, J.; Lu, Q.; Diao, J.; Kuang, Y.; Zhao, N. 3D printed multi-elemental bioceramics induces favorable osteoimmunomodulation for osteogenesis. Ceram. Int. 2025, 51, 23925–23936. [Google Scholar] [CrossRef]
- Ullah, I.; Zhang, W.; Yang, L.; Ullah, M.W.; Atta, O.M.; Khan, S.; Wu, B.; Wu, T.; Zhang, X. Impact of structural features of Sr/Fe co-doped HAp on the osteoblast proliferation and osteogenic differentiation for its application as a bone substitute. Mater. Sci. Eng. C 2020, 110, 110633. [Google Scholar] [CrossRef] [PubMed]
- Wirsig, K.; Kilian, D.; von Witzleben, M.; Gelinsky, M.; Bernhardt, A. Impact of Sr2+and hypoxia on 3D triple cultures of primary human osteoblasts, osteocytes and osteoclasts. Eur. J. Cell Biol. 2022, 101, 151256. [Google Scholar] [CrossRef]
- Cheng, X.; Tan, B.; Wang, S.; Tang, R.; Bao, Z.; Chen, G.; Chen, S.; Tang, W.; Wang, Z.; Long, C.; et al. Rationally designed protein cross-linked hydrogel for bone regeneration via synergistic release of magnesium and zinc ions. Biomaterials 2021, 274, 120895. [Google Scholar] [CrossRef] [PubMed]
- Dai, Q.; Li, M.; Han, X.; Wang, Z.; Ding, Y.; Feng, Q.; Wang, X.; Li, Q.; Cao, X. Co-delivery of Zn ions and resveratrol via bioactive glass-integrated injectable microspheres for postoperative regeneration of bone tumor defects. Compos. Part B Eng. 2024, 272, 111220. [Google Scholar] [CrossRef]
- Yu, J.; Zhang, Y.; Guo, J.; Shu, X.; Lu, Q.; Chen, Q. Sand casting-inspired surface modification of 3D-printed porous polyetheretherketone scaffolds for enhancing osteogenesis. Compos. Part A 2024, 179, 108033. [Google Scholar] [CrossRef]
- Zhang, Y.; Yu, J.; Wu, C.; Han, L.; Tai, Y.; Wang, B.; Yan, Y.; Liu, Y.; Sun, Y.; Lu, Q.; et al. Electrophoretic deposition of curcumin-loaded mesoporous bioactive glass nanoparticle-chitosan composite coatings on titanium for treating tumor-induced bone defect. Compos. Part B 2025, 289, 111950. [Google Scholar] [CrossRef]
- Fernandes, H.R.; Kannan, S.; Alam, M.; Stan, G.E.; Popa, A.C.; Buczyński, R.; Gołębiewski, P.; Ferreira, J.M.F. Two decades of continuous progresses and breakthroughs in the field of bioactive ceramics and glasses driven by CICECO-hub scientists. Bioact. Mater. 2024, 40, 104–147. [Google Scholar] [CrossRef]
- Ye, M.; Zhang, W.; Xu, H.; Xie, P.; Song, L.; Sun, X.; Li, Y.; Wang, S.; Zhao, Q. Fe-doped biodegradable dendritic mesoporous silica nanoparticles for starvation therapy and photothermal-enhanced cascade catalysis in tumor therapy. J. Colloid Interface Sci. 2025, 678, 378–392. [Google Scholar] [CrossRef]
- Schmid, R.; Neffgen, N.; Linden, M. Straightforward adsorption-based formulation of mesoporous silica nanoparticles for drug delivery applications. J. Colloid Interface Sci. 2023, 640, 961–974. [Google Scholar] [CrossRef] [PubMed]
- Dong, J.; Chen, F.; Yao, Y.; Wu, C.; Ye, S.; Ma, Z.; Yuan, H.; Shao, D.; Wang, L.; Wang, Y. Bioactive mesoporous silica nanoparticle-functionalized titanium implants with controllable antimicrobial peptide release potentiate the regulation of inflammation and osseointegration. Biomaterials 2024, 305, 122465. [Google Scholar] [CrossRef] [PubMed]
- Jiang, X.; Guo, J.; Zhang, Y.; Zuo, H.; Bao, Y.; Liu, N.; Guo, M.; Wu, R.; Chen, Q. Electrophoretic deposition of Ag-Cu-CTS coatings on porous titanium with photothermal-responsive antibacterial effect. J. Colloid Interface Sci. 2025, 682, 1116–1126. [Google Scholar] [CrossRef]
- Lu, T.; Li, G.; Zhang, L.; Yuan, X.; Wu, T.; Ye, J. Optimizing silicon doping levels for enhanced osteogenic and angiogenic properties of 3D-printed biphasic calcium phosphate scaffolds: An in vitro screening and in vivo validation study. Mater. Today Bio 2024, 28, 101203. [Google Scholar] [CrossRef] [PubMed]
- Sánchez-Salcedo, S.; García, A.; González-Jiménez, A.; Vallet-Regí, M. Antibacterial effect of 3D printed mesoporous bioactive glass scaffolds doped with metallic silver nanoparticles. Acta Biomater. 2023, 155, 654–666. [Google Scholar] [CrossRef]
- Hammond-Pereira, E.; Zhang, X.; Wu, D.; Saunders, S.R. Precise tuning of silica pore length and pore diameter on silica-encapsulated gold core–shell nanoparticles and catalytic impact. Chem. Eng. J. 2023, 475, 146043. [Google Scholar] [CrossRef]
- Zhang, Y.; Yu, J.; Guo, J.; He, G.; Zhao, Y.; Lu, Q.; Wu, J.; Shu, X.; Lin, X.; Chen, Q. Improving osteogenic and antibacterial properties of porous titanium scaffolds by facile flow-casting of bioactive glass-Ag@MSN coatings. Surf. Coat. Technol. 2023, 459, 129400. [Google Scholar] [CrossRef]
- Rendošová, M.; Gyepes, R.; Kello, M.; Vilkova, M.; Mudroňová, D.; Olejnikova, P.; Cardiano, P.; Gama, S.; Milea, D.; Vargova, Z. Silver(I) pyrrole- and furan-2-carboxylate complexes—From their design and characterization to antimicrobial, anticancer activity, lipophilicity and SAR. J. Inorg. Biochem. 2023, 246, 112266. [Google Scholar] [CrossRef]
- Gao, F.; Shao, T.; Yu, Y.; Xiong, Y.; Yang, L. Surface-bound reactive oxygen species generating nanozymes for selective antibacterial action. Nat. Commun. 2021, 12, 745. [Google Scholar] [CrossRef] [PubMed]
- Moon, H.; Collanton, R.P.; Monroe, J.I.; Casey, T.M.; Shell, M.S.; Han, S.; Scott, S.L. Evidence for Entropically Controlled Interfacial Hydration in Mesoporous Organosilicas. J. Am. Chem. Soc. 2022, 144, 1766–1777. [Google Scholar] [CrossRef] [PubMed]
- Hu, S.; Chen, J.; Hu, Y.; Le, W.; Zhang, P.; Jia, W.; Sun, Q.; Chen, T.; Bao, W.; Cui, Z.; et al. The intensity of cell surface charge defines the malignancy of cancer cells. Chem. Eng. J. 2025, 519, 164948. [Google Scholar] [CrossRef]

| Types of MSNs | SBET/m2 g−1 | DP/nm | VP/cm3 g−1 |
|---|---|---|---|
| Ag@MSNs | 904.6 | 2.65 | 1.15 |
| Ag@MSNs-NH2 | 604.4 | 2.44 | 0.9 |
| Ag@MSNs-COOH | 610.8 | 1.98 | 0.7 |
Disclaimer/Publisher’s Note: The statements, opinions and data contained in all publications are solely those of the individual author(s) and contributor(s) and not of MDPI and/or the editor(s). MDPI and/or the editor(s) disclaim responsibility for any injury to people or property resulting from any ideas, methods, instructions or products referred to in the content. |
© 2025 by the authors. Licensee MDPI, Basel, Switzerland. This article is an open access article distributed under the terms and conditions of the Creative Commons Attribution (CC BY) license (https://creativecommons.org/licenses/by/4.0/).
Share and Cite
Han, L.; Zhang, Y.; Liu, N.; Jing, J.; Zhang, Y.; Chen, Q. Sustained Release of Antibacterial Therapeutic Elements from Functionalized Mesoporous Silica-Coated Silver Nanoparticles for Bone Tissue Engineering. Chemistry 2025, 7, 146. https://doi.org/10.3390/chemistry7050146
Han L, Zhang Y, Liu N, Jing J, Zhang Y, Chen Q. Sustained Release of Antibacterial Therapeutic Elements from Functionalized Mesoporous Silica-Coated Silver Nanoparticles for Bone Tissue Engineering. Chemistry. 2025; 7(5):146. https://doi.org/10.3390/chemistry7050146
Chicago/Turabian StyleHan, Lehao, Yuhan Zhang, Nian Liu, Jiajia Jing, Yanni Zhang, and Qiang Chen. 2025. "Sustained Release of Antibacterial Therapeutic Elements from Functionalized Mesoporous Silica-Coated Silver Nanoparticles for Bone Tissue Engineering" Chemistry 7, no. 5: 146. https://doi.org/10.3390/chemistry7050146
APA StyleHan, L., Zhang, Y., Liu, N., Jing, J., Zhang, Y., & Chen, Q. (2025). Sustained Release of Antibacterial Therapeutic Elements from Functionalized Mesoporous Silica-Coated Silver Nanoparticles for Bone Tissue Engineering. Chemistry, 7(5), 146. https://doi.org/10.3390/chemistry7050146






